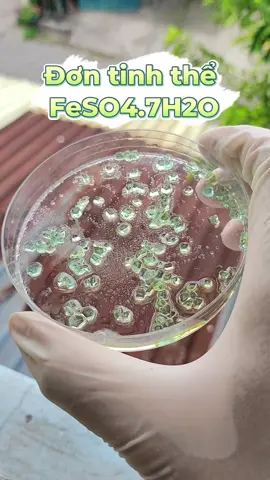

SATUROJACK UPM ✓
Region: MX
Saturday 26 April 2025 01:56:57 GMT
825
203
8
9
Music
Download
Comments
Lxpez_upm 愛 :
Buen edit💗
2025-04-26 16:00:24
2
Bride Alan Lopez Cruz :
🥰🥰🥰
2025-05-06 15:11:20
1
AMADOR_UPM :
buen edit bro
2025-04-26 02:04:46
1
Emanuel_Martinez :
buen edit✨
2025-04-26 01:59:42
1
Chino :
🥰🥰🥰
2025-04-28 02:41:25
0
Angxl :
😍😍😍
2025-04-27 16:33:46
0
Arturio :
I love Mina so much❤️(she is literally beautiful)
2025-04-26 18:56:28
0
ALANRODRIGO_SOTO678 :
🥰🥰🥰
2025-04-26 03:00:25
0
To see more videos from user @saturojack8, please go to the Tikwm
homepage.